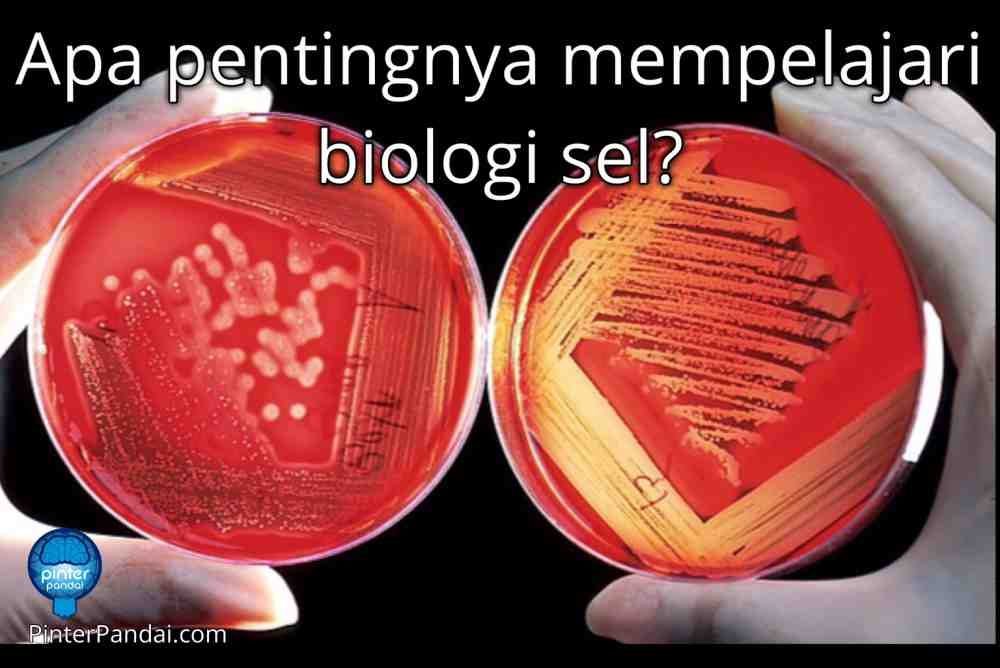
Biologi Sel

Biologi Sel Adalah
Biologi sel atau seluler adalah ilmu yang meneliti satuan dasar dari semua kehidupan, yaitu sel.
Fisiologi mempelajari fungsi fisik dan kimia jaringan organ dan sistem organ suatu organisme.
Hal Yang Dipelajari Dalam Biologi Sel
Mencakup sifat-sifat fisiologis sel seperti struktur dan organel yang terdapat di dalam sel, lingkungan dan antaraksi sel, daur hidup sel, pembelahan sel dan fungsi sel (fisiologi), hingga kematian sel.
Apa Pentingnya Mempelajari Biologi Sel?
Studi tentang sistem biologi di tingkat seluler dan subselular, adalah kunci untuk memahami bagaimana organisme berkembang, bagaimana mereka merespons lingkungan mereka dan bagaimana keadaan berpenyakit berbeda dari keadaan sehat. Kemajuan terbaru dalam biologi sel memungkinkan ahli biologi sel untuk:
Mendeteksi, mencegah dan mengobati penyakit pada sistem hewan dan tumbuhan
Jelajahi proses yang terkait dengan penuaan
Meningkatkan kualitas dan kuantitas tanaman pangan penting
Mengembangkan bahan bakar baru dan berkelanjutan
Kaji dampak perubahan lingkungan terhadap sistem biologi
Biologi Sel dan Kesehatan Manusia
Semua penyakit adalah gangguan pada tingkat sel (Rudolph Virchow, 1858) Untuk mengobati penyakit, kita harus mengerti penyebabnya. Untuk memahami penyebab suatu penyakit, kita harus memahami perubahan yang terjadi pada tingkat sel individu.
Dengan penjelasan genom manusia, kita telah meningkatkan potensi kita untuk menunjukkan adanya penyimpangan molekuler yang bertanggung jawab atas penyakit genetika yang kompleks.
Namun, mengidentifikasi gen mutan atau pola ekspresi gen yang berubah sendiri tidak cukup untuk mengubah informasi ini menjadi pemahaman atau terapi baru.
Fungsi & Konteks Seluler
Fungsi dan konteks seluler dari produk gen ini juga harus dipahami, tes dikembangkan untuk memungkinkan studi mereka, dan model disiapkan untuk menguji terapi baru. Dengan demikian, genomik dan informatika akan semakin bergantung pada biologi sel dan ahli biologi sel.
Selanjutnya, tidak semua penyakit berbasis genetika (penyakit menular, misalnya) dan juga tidak mempengaruhi proses yang mudah dikenali dengan pola ekspresi gen.
Karena studi biologi sel akan menjadi semakin penting untuk mempelajari penyakit, studi tentang dasar seluler penyakit manusia telah menghasilkan beberapa wawasan mendasar tentang prinsip-prinsip biologis sel.
BEBERAPA PENYAKIT UTAMA YANG DIJELASKAN & DIURAIKAN, SEBAGAI AKIBAT ANALISIS BIOLOGI SELULAR SISTEMATIK, TERMASUK:
- Familial hypercholesterolemia (serapan seluler lipoprotein yang tidak stabil; menyebabkan perkembangan “statin”, yang banyak dikonsumsi untuk mengurangi kadar kolesterol).
- Cystic fibrosis (protein transport klorida dilipat ganda dan dipertahankan dalam retikulum endoplasma, gagal mencapai lokasi aksi di permukaan sel).
- Penyakit penyimpanan lisosom (transportasi yang salah dari enzim hidrolitik).
- Penyakit Alzheimer (proses defek protein prekursor plak amiloid).
- Hipertensi (defositosis endositosis saluran natrium).
- Hipertensi (defektif pembentukan kompleks junctional pada sel epitel ginjal).
- Muscular dystrophy (defecive plasma membrane related sitoskeleton).
- Pemfigoid bulosa (gagal kepatuhan di antara sel kulit akibat defek sitoskeleton).
- Cacat pigmentasi (pematangan yang rusak dan pengangkutan butiran melanin dalam melanosom di kulit).
- Beberapa bentuk kanker (transportasi yang salah dari reseptor faktor pertumbuhan, migrasi sel yang menyimpang, cacat mekanisme polaritas sel epitel, cacat dalam regulasi siklus sel).
- Infeksi virus (endositosis, fusi membran).
- Ketulian karena mutasi gen myosin yang mengendalikan mekanotransduksi pada sel telinga bagian dalam.
Teori-Teori Tentang Sel
- Robert Hooke (Inggris, 1665) Kata “sel” itu sendiri berarti “kotak-kotak kosong”, setelah ia mengamati sayatan gabus dengan mikroskop. Hasil pengamatannya ditemukan rongga-rongga yang disebut sel (cellula).
- Hanstein (1880) menyatakan bahwa sel tidak hanya berarti cytos (tempat yang berongga), tetapi juga berarti cella (kantong yang berisi).
- Felix Durjadin (Prancis, 1835) meneliti beberapa jenis sel hidup dan menemukan isi dalam, rongga sel tersebut yang penyusunnya disebut “Sarcode”.
- Johanes Purkinje (1787-1869) mengadakan perubahan nama Sarcode menjadi Protoplasma. disimpulkan bahwa sel terdiri dari kesatuan zat yang dinamakan Protoplasma. menurutnya protoplasma dibagi menjadi dua bagian yaitu Sitoplasma dan Nukleoplasma.
- Matthias Schleiden (ahli botani) dan Theodore Schwann (ahli zoologi) tahun 1838 menemukan adanya kesamaan yang terdapat pada struktur jaringan tumbuhan dan hewan. Mereka mengajukan konsep bahwa makhluk hidup terdiri atas sel . konsep yang diajukan tersebut menunjukkan bahwa sel merupakan satuan structural makhluk hidup.
- Robert Brown (Scotlandia, 1831) menemukan benda kecil yang melayang-layang pada protoplasmayaitu inti (nucleus). dan dikemukakan bahwa Nukleus (inti sel) adalah bagian yang memegang peranan penting dalam sel.
- Max Shultze (1825-1874) ahli anatomi menyatakan sel merupakan kesatuan fungsional makhluk hidup.
- Rudolf Virchow (1858) menyatakan bahwa setiap cel berasal dari cel sebelumnya (omnis celulla ex celulla).
Macam Sel Berdasarkan Keadaan Inti
- Sel prokarion, sel yang intinya tidak memiliki membran, materi inti tersebar dalam sitoplasma (sel yang memiliki satu system membran. Yang termasuk dalam kelompok ini adalah bakteri dan alga biru.
- Sel eukarion, sel yang intinya memiliki membran. Materi inti dibatasi oleh satu system membran terpisah dari sitoplasma. Yang termasuk kelompok ini adalah semua makhluk hidup kecuali bakteri dan alga biru
Sel Prokariotik & Sel Eukariotik
Struktur sel prokariotik lebih sederhana dibandingkan struktur sel eukariotik. Akan tetapi, sel prokariotik mempunyai ribosom (tempat protein dibentuk) yang sangat banyak. Sel prokariotik dan sel eukariotik memiliki beberapa perbedaan sebagai berikut:
Sel Prokariotik
- Tidak memiliki inti sel yang jelas karena tidak memiliki membran inti sel yang dinamakan nucleoid
- Organel-organelnya tidak dibatasi membran
- Membran sel tersusun atas senyawa peptidoglikan
- Diameter sel antara 1-10mm
- Mengandung 4 subunit RNA polymerase
- Susunan kromosomnya sirkuler
Sel Eukariotik
- Memiliki inti sel yang dibatasi oleh membran inti dan dinamakan nucleus
- Organel-organelnya dibatasi membran
- Membran selnya tersusun atas fosfolipid
- Diameter selnya antara 10-100mm
- Mengandungbanyak subunit RNA polymerase
- Susunan kromosomnya linier
Macam Sel Berdasarkan Keadaan Kromosom dan Fungsinya
- Sel Somatis, sel yang menyusun tubuh dan bersifat diploid
- Sel Germinal. sel kelamin yang berfungsi untuk reproduksi dan bersifat haploid.
Bagian-Bagian Sel
- Bagian hidup(komponen protoplasma), terdiri atas inti dan sitoplasma termasuk cairan dan struktur sel seperti : mitokondria, badan golgi, dll.
- Bagian mati (inklusio), terdiri atas dinding sel dan isi vakuola.
Secara anatomis sel dibagi menjadi 3 bagian, yaitu
- Selaput Plasma (Membran Plasma atau Plasmalemma).
- Sitoplasma dan Organel Sel.
- Inti Sel (Nukleus).
Dinding sel
Yaitu selaput atau membran sel yang terletak paling luar yang tersusun dari senyawa kimia Lipoprotein (gabungan dari senyawa lemak atau Lipid dan senyawa protein). Selaput plasma bersifat Selektif Permeabel atau Diferensial Semi Permeabel. Fungsi dari selaput plasma adalah menyelenggarakan transportasi zat dari sel yang satu ke sel yang lain, dengan cara difusi, osmosis, transport aktif dan endositosis atau eksositosis.
Dinding sel hanya terdapat pada sel tumbuhan. Dinding sel terdiri daripada selulosa yang kuat yang dapat memberikan sokongan, perlindungan, dan untuk mengekalkan bentuk sel. Terdapat liang pada dinding sel untuk membenarkan pertukaran bahan di luar dengan bahan di dalam sel.
Dinding sel juga berfungsi untuk menyokong tumbuhan yang tidak berkayu.
Dinding sel terdiri dari Selulosa (sebagian besar), hemiselulosa, pektin, lignin, kitin, garam karbonat dan silikat dari Ca dan Mg.
Sel dikatakan mati apabila sudah tidak mempunyai inti sel dan sitoplasma (kosong). Contohnya sel gabus pada penampang melintang ubi kayu. Sel – sel yang hidup pada umumnya mempunyai dinding sel, inti sel / nukleus, di dalam sel terdapat organel-orgenel/ruang selnya tidak kosong, serta protoplasma.
1. Membran Plasma / Membran Sel
Membran sel merupakan lapisan yang melindungi inti sel dan sitoplasma. Membran sel membungkus organel-organel dalam sel. Suatu lapisan multi fungsional yang memisahkan unsur di dalam sel dengan lingkungan di luar sel. Ketebalannya antara 7 – 10 µm. Tersusun dari lipida, protein, dan ion-ion. Fungsi dinding sel menentukan dalam proses pertukaran zat dan informasi antar sel.Membran sel juga merupakan alat transportasi bagi sel yaitu tempat masuk dan keluarnya zat-zat yang dibutuhkan dan tidak dibutuhkan oleh sel. Struktur membran ialah dua lapis lipid (lipid bilayer) dan memiliki permeabilitas tertentu sehingga tidak semua molekul dapat melalui membran sel.
Struktur membran sel yaitu model mozaik fluida yang dikemukakan oleh Singer dan Nicholson pada tahun 1972.
Teori ini disebut teori membran mozaik cair, yang menjelaskan bahwa membran sel terdiri atas protein yang tersusun seperti mozaik (tersebar) dan masing-masing tersisip di antara dua lapis fosfolipid. Membran sel merupakan bagian terluar sel dan tersusun secara berlapislapis. Bahan penyusun membran sel yaitu lipoprotein yang merupakan gabungan antara lemak dan protein. Membran sel mengandung kira-kira 50% lipid dan 50% protein . Lipid yang menyusun membran sel terdiri atas fosfolipid dan sterol. Fosfolipid memiliki bentuk tidak simetris dan berukuran panjang. Salah satu ujung fosfolipid bersifat mudah larut dalam air (hidrofilik), yang disebut dengan ujung polar. Bagian sterol bersifat tidak larut dalam air (hidrofobik) yang disebut dengan ujung nonpolar.
Fosfolipid tersusun atas dua lapis. Dalam hal ini protein dibedakan menjadi 2 sebagai berikut:
- Protein Ekstrinsik (Perifer)
Protein ini letaknya tersembul di antara dua lapis fosfolipid. Protein ekstrinsik bergabung dengan permukaan luar membran dan bersifat hidrofilik yaitu mudah larut dalam air.
- Protein Intrinsik (Integral)
Protein ini letaknya tenggelam di antara dua lapis fosfolipid. Protein intrinsik bergabung dengan membran dalam dan bersifat hidrofobik yaitu tidak mudah larut dalam air. Penyusun membran sel yang berupa karbohidrat berikatan dengan molekul protein yang bersifat hidrofilik sehingga disebut dengan glikoprotein. Adapun karbohidrat yang berikatan dengan lipid yang bersifat hirofilik disebut dengan glikopolid. Sifat dari membran sel ini adalah selektif permiabel artinya adalah dapat dilalui oleh air dan zat-zat tertentu yang terlarut di dalamnya. Membran sel memiliki fungsi antara lain:- sebagai pelindung sel,
- mengendalikan pertukaran zat, dan
- tempat terjadinya reaksi kimia.
Salah satu fungsi dari membran sel adalah sebagai lalu lintas molekul dan ion secara dua arah. Molekul yang dapat melewati membran sel antara lain ialah molekul hidrofobik (CO2, O2), dan molekul polar yang sangat kecil (air, etanol). Sementara itu, molekul lainnya seperti molekul polar dengan ukuran besar (glukosa), ion, dan substansi hidrofilik membutuhkan mekanisme khusus agar dapat masuk ke dalam sel.
Banyaknya molekul yang masuk dan keluar membran menyebabkan terciptanya lalu lintas membran. Lalu lintas membran digolongkan menjadi dua cara, yaitu dengan transpor pasif untuk molekul-molekul yang mampu melalui membran tanpa mekanisme khusus dan transpor aktif untuk molekul yang membutuhkan mekanisme khusus.
Transpor pasif
Transpor pasif merupakan suatu perpindahan molekul menuruni gradien konsentrasinya. Transpor pasif ini bersifat spontan. Difusi, osmosis, dan difusi terfasilitasi merupakan contoh dari transpor pasif. Difusi terjadi akibat gerak termal yang meningkatkan entropi atau ketidakteraturan sehingga menyebabkan campuran yang lebih acak. Difusi akan berlanjut selama respirasi seluler yang mengkonsumsi O2 masuk. Osmosis merupakan difusi pelarut melintasi membran selektif yang arah perpindahannya ditentukan oleh beda konsentrasi zat terlarut total (dari hipotonis ke hipertonis). Difusi terfasilitasi juga masih dianggap ke dalam transpor pasif karena zat terlarut berpindah menurut gradien konsentrasinya.
Contoh molekul yang berpindah dengan transpor pasif ialah air dan glukosa. Transpor pasif air dilakukan lipid bilayer dan transpor pasif glukosa terfasilitasi transporter. Ion polar berdifusi dengan bantuan protein transpor.
Transpor aktif
Transpor aktif merupakan kebalikan dari transpor pasif dan bersifat tidak spontan. Arah perpindahan dari transpor ini melawan gradien konsentrasi. Transpor aktif membutuhkan bantuan dari beberapa protein. Contoh protein yang terlibat dalam transpor aktif ialah channel protein dan carrier protein, serta ionophore.
Yang termasuk transpor aktif ialah coupled carriers, ATP driven pumps, dan light driven pumps. Dalam transpor menggunakan coupled carriers dikenal dua istilah, yaitu simporter dan antiporter. Simporter ialah suatu protein yang mentransportasikan kedua substrat searah, sedangkan antiporter mentransfer kedua substrat dengan arah berlawanan. ATP driven pump merupakan suatu siklus transpor Na+/K+ ATPase. Light driven pump umumnya ditemukan pada sel bakteri. Mekanisme ini membutuhkan energi cahaya dan contohnya terjadi pada Bakteriorhodopsin.
2. Sitoplasma
Sitoplasma merupakan suatu cairan sel dan segala sesuatu yang larut di dalamnya, kecuali nukleus (inti sel) dan organela. Sitoplasma yang berada di dalam inti sel disebut nukleoplasma. Sitoplasma bersifat koloid kompleks, yaitu tidak padat dan tidak cair. Sifat koloid sitoplasma ini dapat berubahubah tergantung kandungan air. Jika konsentrasi air tinggi maka koloid akan bersifat encer yang disebut dengan sol, sedangkan jika konsentrasi air rendah maka koloid bersifat padat lembek yang disebut dengan gel.
Sitoplasma tersusun atas air yang di dalamnya terlarut molekul-molekul kecil (mikromolekul) dan molekul-molekul besar (makromolekul), ion-ion dan bahan hidup (organela) ukuran partikel terlarut yaitu 0,001 – 1 mikron, dan bersifat transparan.
Bagian yang merupakan lingkungan dalam sel adalah matrik sitoplasma.
Sitoplasma adalah bagian sel yang berupa cairan. Penyusun utama dari Sitoplasma adalah air (90%), berfungsi sebagai pelarut zat-zat kimia serta sebagai media terjadinya reaksi kimia sel. Di dalam sitoplasma terdapat senyawa organik maupun anorganik yang sebagian besar berukuran koloid karena itu protoplasma mempunyai partikel yang terlarut dalam sitoplasma, bergerak ke segala arah (gerak Brown) dan menimbulkan efek Tyndall bila terkena cahaya.
Fungsi Sitoplasma: Tempat metabolisme sitosolik; penyimpanan bahan kimia bagi metabolisme sel misalnya enzim, protein, lemak; Sarana pergerakan organel.
Setiap Organela Memiliki Struktur Dan Fungsi Khusus
Organela yang menyusun sitoplasma adalah sebagai berikut.
Organel ialah salah satu dari beberapa struktur dengan fungsi khusus yang terapung-apung dalam sitoplasma sel eukariot. Contoh organel: contoh organel : kloroplas, plastida, mitokondria, akrosom, sentriol, silium/flagelum, retikulum endoplasma, glioksisom…
A. Retikulum Endoplasma
RETIKULUM ENDOPLASMA (RE) adalah organel yang dapat ditemukan di seluruh sel hewan eukariotik. tapi tidak ditemukan pada sel prokaryotik. Retikulum Endoplasma (RE.)Yaitu struktur berbentuk benang-benang yang bermuara di inti sel. Retikulum endoplasma merupakan sistem yang sangat luas. Dikenal dua jenis RE yaitu : RE. Granuler (Rough E.R)• RE. Agranuler (Smooth E.R)
Fungsi R.E. adalah: sebagai alat transportasi zat-zat di dalam sel itu sendiri. Struktur R.E. hanya dapat dilihat dengan mikroskop elektron. Retikulum endoplasma memiliki struktur yang menyerupai kantung berlapis-lapis. Kantung ini disebut cisternae. Fungsi retikulum endoplasma bervariasi, tergantung pada jenisnya. Retikulum Endoplasma (RE) merupakan labirin membran yang demikian banyak sehingga retikulum endoplasma melipiti separuh lebih dari total membran dalam sel-sel eukariotik. (kata endoplasmik berarti “di dalam sitoplasma” dan retikulum diturunkan dari bahasa latin yang berarti “jaringan”). Komposisi kimia tersusun atas lipoprotein.
3 Jenis Retikulum Endoplasma
-
Retikulum Endoplasma Kasar (REK)
Retikulum endoplasma kasar ditempeli dengan ribosom yang tersebar merata pada permukaannya. Ribosom merupakan tempat sintesis protein. Protein yang sudah terbentuk kemudian akan diangkut ke bagian dalam retikulum endoplasma, dan kemudian disimpan di dalam membran yang berkantong yang disebut vesikula.
RE kasar Di permukaan RE kasar, terdapat bintik-bintik yang merupakan ribosom. Ribosom ini berperan dalam sintesis protein. Maka, fungsi utama RE kasar adalah sebagai tempat sintesis protein. -
Retikulum Endoplasma Halus (REH)RE halus Berbeda dari RE kasar, RE halus tidak memiliki bintik-bintik ribosom di permukaannya.
Permukaan REH ini menghasilkan enzim yang dapat mensintesis fosfolipid, glikolipid, dan steroid. Jadi, secara umum fungsi retikulum endoplasma antara lain:
- penghubung selaput luar inti dengan sitoplasma, sehingga menjadi penghubung materi genetik antara inti sel dengan sitoplasma.
- transpor protein yang disintesis dalam ribosom
- biosintesis fosfolipid, glikolipid, dan sterol.
- berfungsi dalam beberapa proses metabolisme yaitu sintesis lipid, metabolisme karbohidrat dan konsentrasi kalsium, detoksifikasi obat-obatan.
- tempat melekatnya reseptor pada protein membran sel.
-
RE sarkoplasmik
RE sarkoplasmik adalah jenis khusus dari RE halus. RE sarkoplasmik ini ditemukan pada otot licin dan otot lurik. Yang membedakan RE sarkoplasmik dari RE halus adalah kandungan proteinnya. RE halus mensintesis molekul, sementara RE sarkoplasmik menyimpan dan memompa ion kalsium. RE sarkoplasmik berperan dalam pemicuan kontraksi otot.
Fungsi RE, yaitu:
- Mendukung dari supplement mekanik dari struktur koloid dari sitoplasma
- Membantu pertukaran material antara nucleus dan sitoplasma
- Membantu dalam sintesa dan penyimpanan lipid, kolesterol, dan glikogen
Salah satu bagian yang dilewati dari rute perjalanan RNA dari nucleus ke luar sel, yaitu; dari membrane nuclear terus ke pori nuclear terus ke RE terus ke Badan golgi terus ke membrane plasma sampai akhirnya keluar sel.
B. Ribosom (Ergastoplasma)
Ribosom merupakan struktur terkecil yang bergaris tengah 17-20 mikron, letaknya di dalam sitoplasma sehingga hanya bisa dilihat dengan bantuan mikroskop elektron. Semua sel hidup memiliki ribosom. Struktur ini berbentuk bulat terdiri dari dua partikel besar dan kecil, ada yang melekat sepanjang R.E. dan ada pula yang soliter. Ribosom merupakan organel sel terkecil yang tersuspensi di dalam sel.
Fungsi dari ribosom adalah:
Tempat sintesis protein. yang selanjutnya digunakan untuk pertumbuhan, perkembangbiakan atau perbaikan sel yang rusak. Pada sel-sel yang aktif dalam sintesis protein, ribosom dapat berjumlah 25% dari bobot kering sel. Coba sebutkan pada bagian organ mana saja pada tubuh manusia yang paling banyak terdapat ribosom? Keberadaan ribosom secara acak tersebar di dalam sitoplasma, tetapi ada beberapa yang terikat pada membran retikulum endoplasma kasar (REK). Sel hati merupakan sel yang banyak mengandung ribosom, karena sel hati terlibat aktif dalam melakukan sintesis protein.
C. Mitokondria
Mitokondria adalah tempat di mana fungsi respirasi pada makhluk hidup berlangsung. Respirasi merupakan proses perombakan atau katabolisme untuk menghasilkan energi atau tenaga bagi berlangsungnya proses hidup. Dengan demikian, mitokondria adalah “pembangkit tenaga” bagi sel.
Mitokondria banyak terdapat pada sel yang memilki aktivitas metabolisme tinggi dan memerlukan banyak ATP dalam jumlah banyak, misalnya sel otot jantung. Jumlah dan bentuk mitokondria bisa berbeda-beda untuk setiap sel. Mitokondria berbentuk elips dengan diameter 0,5 µm dan panjang 0,5 – 1,0 µm. Jumlah mitokondria di dalam sel rata-rata 200 – 300 mitokondria. Struktur mitokondria terdiri dari empat bagian utama, yaitu membran luar, membran dalam, ruang antar membran, dan matriks yang terletak di bagian dalam membran [Cooper, 2000].
Membran luar terdiri dari protein dan lipid dengan perbandingan yang sama serta mengandung protein porin yang menyebabkan membran ini bersifat permeabel terhadap molekul-molekul kecil yang berukuran 6000 Dalton. Dalam hal ini, membran luar mitokondria menyerupai membran luar bakteri gram-negatif. Selain itu, membran luar juga mengandung enzim yang terlibat dalam biosintesis lipid dan enzim yang berperan dalam proses transpor lipid ke matriks untuk menjalani β-oksidasi menghasilkan Asetil KoA.
Membran dalam yang kurang permeabel dibandingkan membran luar terdiri dari 20% lipid dan 80% protein.
Membran ini merupakan tempat utama pembentukan ATP. Luas permukaan ini meningkat sangat tinggi diakibatkan banyaknya lipatan yang menonjol ke dalam matriks, disebut krista [Lodish, 2001]. Stuktur krista ini meningkatkan luas permukaan membran dalam sehingga meningkatkan kemampuannya dalam memproduksi ATP. Membran dalam mengandung protein yang terlibat dalam reaksi fosforilasi oksidatif, ATP sintase yang berfungsi membentuk ATP pada matriks mitokondria, serta protein transpor yang mengatur keluar masuknya metabolit dari matriks melewati membran dalam.
Ruang antar membran yang terletak diantara membran luar dan membran dalam merupakan tempat berlangsungnya reaksi-reaksi yang penting bagi sel, seperti siklus Krebs, reaksi oksidasi asam amino, dan reaksi β-oksidasi asam lemak. Di dalam matriks mitokondria juga terdapat materi genetik, yang dikenal dengan DNA mitkondria (mtDNA), ribosom, ATP, ADP, fosfat inorganik serta ion-ion seperti magnesium, kalsium dan kalium
Peran dan fungsi mitokondria:
- Sebagai organel yang menghasilkan energi selama proses respirasi pada siklus crebs dan transport electron yang menghasilkan ATP.
- Mengakumulasikan ion-ion seperti Ca2++ dan Fe3++.
D. Lisosom
Lisosom adalah organel sel berupa kantong terikat membran yang berisi enzim hidrolitik yang berguna untuk mengontrol pencernaan intraseluler pada berbagai keadaan. Lisosom ditemukan pada tahun 1950 oleh Christian de Duve dan ditemukan pada semua sel eukariotik. Di dalamnya, organel ini memiliki 40 jenis enzim hidrolitik asam seperti protease, nuklease, glikosidase, lipase, fosfolipase, fosfatase, ataupun sulfatase. Semua enzim tersebut aktif pada pH 5.
Lisosom hanya ditemukan pada sel hewan saja.
Lisosom merupakan struktur agak bulat yang dibatasi membran tunggal, memiliki ukuran diameter 1,5 mikron. Lisosom berperan aktif melakukan fungsi imunitas. Lisosom berisi enzim-enzim hidrolitik untuk memecah polisakarida, lipid, fosfolipid, dan protein. Lisosom berperan dalam pencernaan intrasel, misalnya pada protozoa atau sel darah putih.
Lisosom juga berperan penting dalam matinya sel-sel. Lisosom banyak terdapat pada sel-sel darah terutama leukosit, limfosit, dan monosit. Di dalam sel-sel tersebut lisosom berperan mensintesis enzim-enzim hidrolitik untuk mencernakan bakteri-bakteri patogen yang menyerang tubuh. Agar dapat memahami struktur lisosom. Lisosom membantu menghancurkan sel yang luka atau mati dan menggantikan dengan yang baru yang disebut dengan autofagus.
Contohnya lisosom banyak terdapat pada sel-sel ekor kecebong.
Ekor kecebong secara bertahap akan diserap dan mati. Hasil penghancurannya digunakan untuk pertumbuhan sel-sel baru bagi katak yang sedang dalam masa pertumbuhan. Begitu pula selaput antara jari-jari tangan dan kaki manusia ketika berujud embrio akan hilang setelah embrio tersebut lahir.
Fungsi utama lisosom adalah endositosis, fagositosis, dan autofagi. serta sebagai penghasil dan penyimpan enzim pencernaan seluler (autofagi, autolysis,eksositosis). Enzim-enzim yang terdapat di dalam Lisosom misalnya Lisozym, Profase, Lipase dan Asam fosfatase.
- Endositosis ialah pemasukan makromolekul dari luar sel ke dalam sel melalui mekanisme endositosis, yang kemudian materi-materi ini akan dibawa ke vesikel kecil dan tidak beraturan, yang disebut endosom awal. Beberapa materi tersebut dipilah dan ada yang digunakan kembali (dibuang ke sitoplasma), yang tidak dibawa ke endosom lanjut. Di endosom lanjut, materi tersebut bertemu pertama kali dengan enzim hidrolitik. Di dalam endosom awal, pH sekitar 6. Terjadi penurunan pH (5) pada endosom lanjut sehingga terjadi pematangan dan membentuk lisosom.
- Proses autofagi digunakan untuk pembuangan dan degradasi bagian sel sendiri, seperti organel yang tidak berfungsi lagi. Mula-mula, bagian dari retikulum endoplasma kasar menyelubungi organel dan membentuk autofagosom. Setelah itu, autofagosom berfusi dengan enzim hidrolitik dari trans Golgi dan berkembang menjadi lisosom (atau endosom lanjut). Proses ini berguna pada sel hati, transformasi berudu menjadi katak, dan embrio manusia.
- Fagositosis merupakan proses pemasukan partikel berukuran besar dan mikroorganisme seperti bakteri dan virus ke dalam sel. Pertama, membran akan membungkus partikel atau mikroorganisme dan membentuk fagosom. Kemudian, fagosom akan berfusi dengan enzim hidrolitik dari trans Golgi dan berkembang menjadi lisosom (endosom lanjut).
E. Badan Golgi (Apparatus Golgi = Diktiosom)
Organela ini ditemukan pertama kali oleh Camilio Golgi, seorang ilmuwan dari Italia. Badan golgi biasa dijumpai pada sel tumbuhan maupun hewan. Pada sel hewan terdapat 10-20 badan golgi. Lain halnya dengan tumbuhan yang memiliki ratusan badan golgi pada setiap sel. Badan Golgi pada tumbuhan biasanya disebut diktiosom.
Badan golgi terdiri atas sekelompok kantong pipih yang dibatasi membran yang dinamakan saccula. Di dekat saccula terdapat vesikel sekretori yang berupa gelembung bulat. Badan golgi pada tumbuhan disebut dengan diktiosom. Pada diktiosom terjadi pembuatan polisakarida dalam bentuk selulosa yang digunakan sebagai bahan penyusun dinding sel.
Badan Golgi (disebut juga aparatus Golgi, kompleks Golgi atau diktiosom) adalah organel yang dikaitkan dengan fungsi ekskresi sel, dan struktur ini dapat dilihat dengan menggunakan mikroskop cahaya biasa. Organel ini terdapat hampir di semua sel eukariotik dan banyak dijumpai pada organ tubuh yang melaksanakan fungsi ekskresi, misalnya ginjal.
Beberapa fungsi badan golgi antara lain:
- Membentuk kantung (vesikula) untuk sekresi (protein, glikoprotein, karbohidrat, lemak). Terjadi terutama pada sel-sel kelenjar kantung kecil tersebut, berisi enzim dan bahan-bahan lain.
- menghasilkan enzim yang belum aktif (zimogen) dan pembentuk lisosom.
- Membentuk membran plasma. Kantung atau membran golgi sama seperti membran plasma. Kantung yang dilepaskan dapat menjadi bagian dari membran plasma.
- Membentuk dinding sel tumbuhan
- Fungsi lain ialah dapat membentuk akrosom pada spermatozoa yang berisi enzim untuk memecah dinding sel telur dan pembentukan lisosom.
- Tempat untuk memodifikasi protein
- Untuk menyortir dan memaket molekul-molekul untuk sekresi sel
- Untuk membentuk lisosom
- dalam sintesis polysakarida
- dalam formasi sel dengan cara mentransfer polysakarida yang dibentuk di badan golgi ke daerah sel yang baru pada saat sel masih dalam pertumbuhan
- Berperan dalam formasi pigmen, seperti pigmen melanin.
F. Sentriol (sentrosom)
sentrosom berfungsi dalam pembelahan sel (Mitosis maupun Meiosis). Sentrosom bertindak sebagai benda kutub dalam mitosis dan meiosis. Struktur ini hanya dapat dilihat dengan menggunakan mikroskop elektron.
Sentrosom hanya dijumpai pada sel hewan.
Bentuk sentrosom bulat kecil. Organela ini terdapat di dekat inti, berperan dalam proses pembelahan sel. Sentrosom menyerupai bola-bola duri karena adanya serat-serat radial.
Sentorom merupakan wilayah yang terdiri dari dua sentriol (sepasang sentriol) yang terjadi ketika pembelahan sel, dimana nantinya tiap sentriol ini akan bergerak ke bagian kutub-kutub sel yang sedang membelah. Pada siklus sel di tahapan interfase, terdapat fase S yang terdiri dari tahap duplikasi kromoseom, kondensasi kromoson, dan duplikasi sentrosom.
Terdapat sejumlah fase tersendiri dalam duplikasi sentrosom, dimulai dengan G1 dimana sepasang sentriol akan terpisah sejauh beberapa mikrometer. Kemudian dilanjutkan dengan S, yaitu sentirol anak akan mulai terbentuk sehingga nanti akan menjadi dua pasang sentriol. Fase G2 merupakan tahapan ketika sentriol anak yang baru terbentuk tadi telah memanjang. Terakhir ialah fase M dimana sentriol bergerak ke kutub-kutub pembelahan dan berlekatan dengan mikrotubula yang tersusun atas benang-benang spindel.
G. Vakuola
Vakuola ialah organela sitoplasmik yang berisi cairan dan dibatasi selaput tipis yang disebut tonoplas. Beberapa ahli tidak memasukkan vakuola sebagai organel sel. Benda ini dapat dilihat dengan mikroskop cahaya biasa. Selaput pembatas antara vakuola dengan sitoplasma disebut Tonoplas
Vakuola berisi cairan (cell sap dalam bahasa Inggris) yang di dalamnya terlarut garam-garam organik, glikosida, enzim, lipid, alkaloid, garam mineral, asam, dan basa, tanin (zat penyamak), minyak eteris (misalnya Jasmine pada melati, Roseine pada mawar Zingiberine pada jahe), alkaloid (misalnya Kafein, Kinin, Nikotin,
Likopersin dan lain-lain, enzim, butir-butir patiPada boberapa spesies dikenal adanya vakuola kontraktil dan vaknola non kontraktil. Pada sel tumbuhan, vakuola selalu ada namun tidak dijumpai pada sel hewan dan bakteri, kecuali pada hewan uniseluler tingkat rendah.
Semakin tua suatu tumbuhan, maka vakuola yang terbentuk semakin besar. Vakuola berperan untuk menyimpan zat makanan berupa sukrosa dan garam mineral, selain juga berfungsi sebagai tempat penimbunan sisa metabolisme, seperti getah pada batang tumbuhan karet.
Fungsi vakuola:
- memelihara tekanan osmotik sel
- penyimpanan hasil sintesa berupa glikogen, fenol, dll
- mengadakan sirkulasi zat dalam sel
- Menyimpan bahan makanan (air, garam, mineral, protein, gula,asam organik, asam amino).
- Berperan dalam turgiditas (turgor sel) dan bentuk sel.
- Dapat memberi warna pada bunga dan buah karena mengandung pigmen antosian yang berguna untuk menarik serangga, burung, dan hewan lain yang berjasa bagi penyerbukan dan pemencaran biji.
- Sebagai lisosom (berisi enzim) dapat mencerna sitoplasma ketika sel mati dan tonoplas pecah menyebabkan autolisis.
- Tempat penimbunan sisa metabolisme : kristal Ca oksalat, alkaloid, tanin, lateks.
Vakuola juga terdapat pada protozoa. Vakuola protozoa berupa vakuola kontraktil dan vakuola nonkontraktil.
- Vakuola kontraktil
Vakuola kontraktil disebut juga vakuola berdenyut. Vakuola kontraktil memiliki fungsi sebagai osmoregulator yaitu mengatur nilai osmotik dalam sel.
- Vakuola nonkontraktil
Vakuola nonkontraktil disebut juga vakuola makanan, yang berfungsi untuk mencerna makanan dan mengedarkan hasil pencernaan makanan ke seluruh tubuh.
H. Mikrotubulus
Mikrotubulus Berbentuk benang silindris, kaku, berfungsi untuk mempertahankan bentuk sel dan sebagai “rangka sel”. Contoh organel ini antara lain benang-benang gelembung pembelahan Selain itu mikrotubulus berguna dalam pembentakan Sentriol, Flagela dan Silia.
I. Mikrofilamen
Mikrofilamen seperti Mikrotubulus, tetapi lebih lembut. Terbentuk dari komponen utamanya yaitu protein aktin dan miosin (seperti pada otot). Mikrofilamen berperan dalam pergerakan sel.k. Peroksisom (Badan Mikro) Ukurannya sama seperti Lisosom. Organel ini senantiasa berasosiasi dengan organel lain, dan banyak mengandung enzim oksidase dan katalase (banyak disimpan dalam sel-sel hati).
J. Plastida
Plastida juga merupakan organela spesifik yang terdapat pada sel tumbuhan. Di dalam plastida terdapat zat pigmen. Plastida adalah organel sel yang menghasilkan warna pada sel tumbuhan. Mekanisme kerja plastida sangat dipengaruhi oleh rangsang cahaya. Pada lingkungan yang banyak terdapat penyinaran matahari, maka plastida menghasilkan pigmen warna yang disebut kloroplas, antara lain pigmen hijau (klorofil), kuning (xantin), dan kuning kemerah-merahan (xantofil).
Plastida yang tidak terkena cahaya matahari tidak akan menghasilkan pigmen warna yang disebut leukoplas atau amiloplas yaitu untuk tempat amilum.
3 macam plastida, yaitu:
- Leukoplast: plastida yang berbentuk amilum(tepung). (plastida berwarna putih. Plastida ini berfungsi sebagai penyimpan makanan).
- Amiloplas : Menyimpan amilum.
- Elaioplas : Menyimpan lemak/minyak.
- Proteoplas : Menyimpan protein.
- Kloroplast : plastida yang umumnya berwarna hijau. terdiri dari : klorofil a dan b (untuk fotosintesis), xantofil, dan karoten
- Plastida yang banyak mengandung karoten
Kromoplas (plastida yang mengandung pigmen selain hijau yaitu kuning dan jingga). Karotin, Xantofil.
Nukleus
Nukleus merupakan organ terbesar sel, dengan ukuran diameter antara 10-20 nm. Nukleus memiliki bentuk bulat atau lonjong. Inti sel atau nukleus sel adalah organel yang ditemukan pada sel eukariotik. Organel ini mengandung sebagian besar materi genetik sel dengan bentuk molekul DNA linear panjang yang membentuk kromosom bersama dengan beragam jenis protein seperti histon. Gen di dalam kromosom-kromosom inilah yang membentuk genom inti sel.
Fungsi utama nukleus adalah untuk menjaga integritas gen-gen tersebut dan mengontrol aktivitas sel dengan mengelola ekspresi gen. Selain itu, nukleus juga berfungsi untuk mengorganisasikan gen saat terjadi pembelahan sel, memproduksi mRNA untuk mengkodekan protein, sebagai tempat sintesis ribosom, tempat terjadinya replikasi dan transkripsi dari DNA, serta mengatur kapan dan di mana ekspresi gen harus dimulai, dijalankan, dan diakhiri
Hampir semua sel memiliki nukleus,kecuali pada bakteri dan alga biru hijau.karena nukleus ini berperan penting dalam aktivitas sel, terutama dalam melakukan sintesis protein. Namun ada beberapa sel yang tidak memiliki nukleus antara lain sel eritrosit dan sel trombosit. Pada kedua sel ini aktivitas metabolisme terbatas dan tidak dapat melakukan pembelahan. Biasanya sebuah sel hanya memiliki satu nukleus saja, yang terletak di tengah. Namun ada sel-sel yang memiliki inti lebih dari satu yaitu pada sel parenkim hati dan sel otot jantung, yang memiliki dua buah nukleus. Adapun pada sel otot rangka terdapat banyak nukleus. Komposisi nukleus terdiri atas membran nukleus, matriks, dan anak inti.
-
Membran Nukleus (Karioteka)
Susunan molekul membran ini sama dengan susunan molekul membran sel, yaitu berupa lipoprotein. Membran inti juga dilengkapi dengan poripori yang dapat memungkinkan hubungan antara nukleoplasma dan sitoplasma. Pori-pori ini berperan dalam memindahkan materi antara inti sel dan sitoplasmanya. Membran inti hanya bisa dilihat dengan jelas dengan menggunakan mikroskop elektron. Membran inti terdiri atas dua selaput yaitu selaput luar dan selaput dalam. Selaput luar mengandung ribosom pada sisi yang menghadap sitoplasma dan sering kali berhubungan dengan membran retikulum endoplasma.
-
Matriks (Nukleoplasma)
Nukleoplasma terdiri atas cairan inti yang tersusun dari zat protein inti yang disebut dengan nukleoprotein.
-
Anak Inti (Nukleolus)
Di dalam nukleolus banyak terkandung kromosom, yaitu benang-benang halus DNA. Kromosom tersebut berfungsi untuk:
- menentukan ciri-ciri yang dimiliki sel.
- mengatur bentuk sel.
- menentukan generasi selanjutnya.
DNA tersusun dalam kromosom yang terdapat pada nukleoplasma, sedangkan tempat sintesis RNA terjadi pada nukleolus.
Fungsi nukleus, yaitu:
- Sebagai pengatur pada sintesa protein
- Mengatur pertumbuhan dan reproduksi tumbuhan
Sel-sel khusus:
- Sel Tidak Berinti, contohnya trombosit dan eritrosit (Sel darah merah). Di dalam sel darah merah, terdapat hemoglobin sebagai pengganti nukleus (inti sel).
- Sel Berinti Banyak, contohnya Paramecium sp dan sel otot
- Sel hewan berklorofil, contohnya euglena sp. Euglena sp adalah hewan uniseluler berklorofil.
- Sel pendukung, contohnya adalah sel xilem. Sel xilem akan mati dan meninggalkan dinding sel sebagai “tulang” dan saluran air. Kedua ini sangatlah membantu dalam proses transpirasi pada tumbuhan.
Sel tumbuhan, sel hewan, dan sel bakteri mempunyai beberapa perbedaan seperti berikut
| Sel tumbuhan | Sel hewan | Sel bakteri |
| Sel tumbuhan lebih besar daripada sel hewan. | Sel hewan lebih kecil daripada sel tumbuhan. | Sel bakteri sangat kecil. |
| Mempunyai bentuk yang tetap. | Tidak mempunyai bentuk yang tetap. | Mempunyai bentuk yang tetap. |
| Mempunyai dinding sel [cell wall] dari selulosa. | Tidak mempunyai dinding sel [cell wall]. | Mempunyai dinding sel [cell wall] dari lipoprotein. |
| Mempunyai plastida. | Tidak mempunyai plastida. | Tidak mempunyai plastida. |
| Mempunyai vakuola [vacuole] atau rongga sel yang besar. | Tidak mempunyai vakuola [vacuole], walaupun kadang-kadang sel beberapa hewan uniseluler memiliki vakuola (tapi tidak sebesar yang dimiliki tumbuhan). Yang biasa dimiliki hewan adalah vesikel atau [vesicle]. | Tidak mempunyai vakuola. |
| Menyimpan tenaga dalam bentuk butiran (granul) pati. | Menyimpan tenaga dalam bentuk butiran (granul) glikogen. | – |
| Tidak Mempunyai sentrosom [centrosome]. | Mempunyai sentrosom [centrosome]. | Tidak Mempunyai sentrosom [centrosome]. |
| Tidak memiliki lisosom [lysosome]. | Memiliki lisosom [lysosome]. | |
| Nukleus lebih kecil daripada vakuola. | Nukleus lebih besar daripada vesikel. | Tidak memiliki nukleus dalam arti sebenarnya. |
| jumlah mitokondria relatif banyak | jumlah mitokondria relatif sedikit karena fungsinya dibantu oleh butir plastida | |
| vakuola sedikit tapi ukurannya besar | vakuolanya banyak dengan ukuran yang relatif kecil | |
| sentrosom dan sentriolnya tidak jelas | sentrosom dan sentriol tampak jelas |
Secara umum, perbedaan antara hewan & tumbuhan dapat dinyatakan sebagai berikut
| Hewan | Tumbuhan |
| Terdapat sentriol | Tidak ada sentriol |
| Tidak ada pembentukan dinding sel | Terdapat sitokinesis dan pembentukan dinding sel |
| Ada kutub animal dan vegetal | Tidak ada perbedaan kutub embriogenik, yang ada semacam epigeal dan hipogeal |
| Jaringan sel hewan bergerak menjadi bentuk yang berbeda | Jaringan sel tumbuhan tumbuh menjadi bentuk yang berbeda |
| Terdapat proses gastrulasi | Terdapat proses histodiferensiasi |
| Tidak terdapat jaringan embrionik seumur hidup | Meristem sebagai jaringan embrionik seumur hidup |
| Terdapat batasan pertumbuhan (ukuran tubuh) | Tidak ada batasan pertumbuhan, kecuali kemampuan akar dalam hal menopang berat tubuh bagian atas |
| Apoptosis untuk perkembangan jaringan, melibatkan mitokondria dan caspase | Tidak ada “Apoptosis”, yang ada lebih ke arah proteksi diri, tidak melibatkan mitokondria |
Sumber : materi biologi oleh dosen Natar Fitri N, S.Kep., NS;2011;Biologi Sel ;Yogyakarta:STIKES Bethesda Yakkum Yogyakata
Bacaan Lainnya
- Sebagian cabang biologi: Hematologi
- Sebagian Cabang Dari Biologi: Biomusikologi
- 10 Cara Kerja Cerdas Untuk Menjadi Lebih Produktif Dan Pekerjaan Menjadi Cepat Selesai
- Tes Ketelitian Otak & 10 Cara Menjadi Lebih Teliti Dan Pasti Berhasil
- Kepalan Tangan Menandakan Karakter Anda & Kepalan nomer berapa yang Anda miliki?
Kuis Biologi Sel
Sumber bacaan: Yale School of Medicine, NCBI
Pinter Pandai “Bersama-Sama Berbagi Ilmu”
Quiz | Matematika | IPA | Geografi & Sejarah | Info Unik | Lainnya